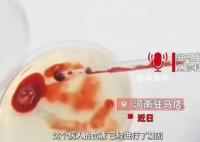

-
 8岁女孩趴在去世3年姥姥照片上流泪 引无数网友泪目2023-10-13 16:34:41近日,河南开封。8岁女孩放学后趴过世姥姥照片上默默流泪,引无数网友泪目。孩子妈妈姬女士称,孩子从小被她姥姥带大,和姥姥感情非常好。
8岁女孩趴在去世3年姥姥照片上流泪 引无数网友泪目2023-10-13 16:34:41近日,河南开封。8岁女孩放学后趴过世姥姥照片上默默流泪,引无数网友泪目。孩子妈妈姬女士称,孩子从小被她姥姥带大,和姥姥感情非常好。 -
 男子误喝防冻液血液呈胶冻状离世 治疗无效不幸去世2023-10-13 16:32:01近日,河南驻马店一位勤劳的男子,因一次意外,生命永远定格在60岁。而这起悲剧的起因,却仅仅是一瓶看似无害的汽车防冻液。据悉,这位男子
男子误喝防冻液血液呈胶冻状离世 治疗无效不幸去世2023-10-13 16:32:01近日,河南驻马店一位勤劳的男子,因一次意外,生命永远定格在60岁。而这起悲剧的起因,却仅仅是一瓶看似无害的汽车防冻液。据悉,这位男子 -
男子误喝防冻液血液成胶冻状离世 生命永远定格在60岁2023-10-13 16:30:38近日,河南驻马店一位勤劳的男子,因一次意外,生命永远定格在60岁。而这起悲剧的起因,却仅仅是一瓶看似无害的汽车防冻液。据悉,这位男子
男子误喝防冻液血液成胶冻状离世 生命永远定格在60岁2023-10-13 16:30:38近日,河南驻马店一位勤劳的男子,因一次意外,生命永远定格在60岁。而这起悲剧的起因,却仅仅是一瓶看似无害的汽车防冻液。据悉,这位男子 -
 京东港股大跌 京东物流股价下跌4.15%至9.48港元2023-10-13 16:28:5210月13日,京东港股股价遭遇今年以来最大跌幅。截至上午休市,京东港股股价下跌12 06%至103 5港元。除了京东,京东系其他公司股价也有所下
京东港股大跌 京东物流股价下跌4.15%至9.48港元2023-10-13 16:28:5210月13日,京东港股股价遭遇今年以来最大跌幅。截至上午休市,京东港股股价下跌12 06%至103 5港元。除了京东,京东系其他公司股价也有所下 -
 孙海洋落泪:不接受判决 将提起抗诉2023-10-13 16:27:11时隔半年,电影《亲爱的》原型孙海洋之子孙卓被拐案迎来宣判。2023年10月13日下午,深圳市南山区人民法院以拐骗儿童罪判处吴某龙有期徒刑五
孙海洋落泪:不接受判决 将提起抗诉2023-10-13 16:27:11时隔半年,电影《亲爱的》原型孙海洋之子孙卓被拐案迎来宣判。2023年10月13日下午,深圳市南山区人民法院以拐骗儿童罪判处吴某龙有期徒刑五 -
 郑州楼市高库存的“极限拉扯”2023-10-13 16:24:19约两个月前的8月3日,郑州市颁布认房不认贷政策,成为全国第一个率先出台该政策的省会城市。郑州一直是房地产市场中,被重点聚焦的城市之一
郑州楼市高库存的“极限拉扯”2023-10-13 16:24:19约两个月前的8月3日,郑州市颁布认房不认贷政策,成为全国第一个率先出台该政策的省会城市。郑州一直是房地产市场中,被重点聚焦的城市之一 -
 男子当街鞭打女子长达8分钟 警方通报2023-10-13 16:22:5310月10日,山东一男子当街鞭打女子长达8分钟,引发关注。13日,当地警方通报称,打人者已被依法采取刑事拘留措施。诈骗一案,公安机关已侦
男子当街鞭打女子长达8分钟 警方通报2023-10-13 16:22:5310月10日,山东一男子当街鞭打女子长达8分钟,引发关注。13日,当地警方通报称,打人者已被依法采取刑事拘留措施。诈骗一案,公安机关已侦 -
 孙卓符建涛被拐案2被告获刑5年、2年2023-10-13 16:21:402023年10月13日,深圳市南山区人民法院依法对被告人吴某龙拐骗儿童、吴某光包庇一案作出一审公开宣判,以拐骗儿童罪判处吴某龙有期徒刑五年
孙卓符建涛被拐案2被告获刑5年、2年2023-10-13 16:21:402023年10月13日,深圳市南山区人民法院依法对被告人吴某龙拐骗儿童、吴某光包庇一案作出一审公开宣判,以拐骗儿童罪判处吴某龙有期徒刑五年 -
 媒体:国际金价未来波动或加大2023-10-13 16:20:02今年以来,国际金价上演过山车行情。国际黄金期货年内涨幅最高一度接近14%,而近期连续九个交易日下跌,跌幅达6 24%。最新报告指出,尽管近
媒体:国际金价未来波动或加大2023-10-13 16:20:02今年以来,国际金价上演过山车行情。国际黄金期货年内涨幅最高一度接近14%,而近期连续九个交易日下跌,跌幅达6 24%。最新报告指出,尽管近 -
 员工参加公司蛙跳游戏致十级伤残 法院判决公司承担70%的赔偿责任2023-10-13 16:18:13员工在参加公司活动的时候不慎受伤能否要求公司进行赔偿呢?近日,苏州太仓市人民法院就审结了这样一起案件2022年,年过50岁的李某,与太仓
员工参加公司蛙跳游戏致十级伤残 法院判决公司承担70%的赔偿责任2023-10-13 16:18:13员工在参加公司活动的时候不慎受伤能否要求公司进行赔偿呢?近日,苏州太仓市人民法院就审结了这样一起案件2022年,年过50岁的李某,与太仓 -
 郑州一加油站爆炸?谣言2023-10-13 16:17:02据@郑州消防微博通报,10月13日12时31分,郑州市消防救援支队接警:惠济区中州大道与S312辅路交叉口一仓库起火。指挥中心迅速调派临近消防
郑州一加油站爆炸?谣言2023-10-13 16:17:02据@郑州消防微博通报,10月13日12时31分,郑州市消防救援支队接警:惠济区中州大道与S312辅路交叉口一仓库起火。指挥中心迅速调派临近消防 -
 媒体:“负面流量”不是谋利工具2023-10-13 16:13:52刘暖曦直播被禁,也是对类似负面人设负面流量的一次警示。近日,刘暖曦直播4次后被投诉永久禁播的消息引发网友热议。据媒体报道,有网友发
媒体:“负面流量”不是谋利工具2023-10-13 16:13:52刘暖曦直播被禁,也是对类似负面人设负面流量的一次警示。近日,刘暖曦直播4次后被投诉永久禁播的消息引发网友热议。据媒体报道,有网友发 -
 碧桂园创始人卖私人飞机偿债 目前公司9只境内债已成功展期2023-10-13 16:11:58针对日前市场传出碧桂园创始人杨国强已卖私人飞机偿债的消息,相关知情人士告诉记者,已卖掉一架,另一架还在卖。其中卖掉的那架为新飞机,
碧桂园创始人卖私人飞机偿债 目前公司9只境内债已成功展期2023-10-13 16:11:58针对日前市场传出碧桂园创始人杨国强已卖私人飞机偿债的消息,相关知情人士告诉记者,已卖掉一架,另一架还在卖。其中卖掉的那架为新飞机, -
 奔驰无视鸣笛强行变道出事故 网友争议后车该让行2023-10-13 16:08:5710月10日,在上海一辆奔驰车试图变道,直行车鸣笛提醒,但司机仍然强行并线。直行的车主坚决不让,直接将奔驰车撞上,使其横在马路上。事故
奔驰无视鸣笛强行变道出事故 网友争议后车该让行2023-10-13 16:08:5710月10日,在上海一辆奔驰车试图变道,直行车鸣笛提醒,但司机仍然强行并线。直行的车主坚决不让,直接将奔驰车撞上,使其横在马路上。事故 -
 男子欠债30万法院扣押109双球鞋 不日将进行拍卖2023-10-13 16:08:14近日,湖北武汉,因被执行人欠付30万元拒不偿还,江汉区法院在一起借贷案件中扣押了被执行人名下109双球鞋,多为限量版,不日将进行拍卖。
男子欠债30万法院扣押109双球鞋 不日将进行拍卖2023-10-13 16:08:14近日,湖北武汉,因被执行人欠付30万元拒不偿还,江汉区法院在一起借贷案件中扣押了被执行人名下109双球鞋,多为限量版,不日将进行拍卖。 -
 东方甄选向网红铁头发律师函 将采取必要措施维护自身合法权益2023-10-13 16:06:22针对铁头称将打假东方甄选的消息,东方甄选发布公告称,近日,某网络主播假借打假之名,歪曲事实,恶意维权,发布大量抹黑东方甄选的言论,
东方甄选向网红铁头发律师函 将采取必要措施维护自身合法权益2023-10-13 16:06:22针对铁头称将打假东方甄选的消息,东方甄选发布公告称,近日,某网络主播假借打假之名,歪曲事实,恶意维权,发布大量抹黑东方甄选的言论, -
 京东回应网传刘姓商人涉嫌违法被抓 目前已向公安机关报案2023-10-13 16:04:5510月13日,京东回应刘姓商人涉嫌违法被抓谣言称,谣言被别有用心的人刻意发布在京东相关新闻动态下,以混淆视听、操纵舆论,目前已向公安机
京东回应网传刘姓商人涉嫌违法被抓 目前已向公安机关报案2023-10-13 16:04:5510月13日,京东回应刘姓商人涉嫌违法被抓谣言称,谣言被别有用心的人刻意发布在京东相关新闻动态下,以混淆视听、操纵舆论,目前已向公安机 -
 媒体:鼓励生育不能只盯着二孩2023-10-13 13:48:0610月12日,国家卫生健康委发布《2022年我国卫生健康事业发展统计公报》,披露了我国人口生育相关数据,2022年出生人口956万人,其中二孩占
媒体:鼓励生育不能只盯着二孩2023-10-13 13:48:0610月12日,国家卫生健康委发布《2022年我国卫生健康事业发展统计公报》,披露了我国人口生育相关数据,2022年出生人口956万人,其中二孩占 -
 江歌妈妈回应刘暖曦直播:真想说几句2023-10-13 13:46:49近日,刘暖曦(曾用名刘鑫)直播4次后被投诉永久禁播的消息,引发网友热议。10月13日, 朋友称刘暖曦直播是为了修复心理 登上热搜一。对此,
江歌妈妈回应刘暖曦直播:真想说几句2023-10-13 13:46:49近日,刘暖曦(曾用名刘鑫)直播4次后被投诉永久禁播的消息,引发网友热议。10月13日, 朋友称刘暖曦直播是为了修复心理 登上热搜一。对此, -
 大学物理老师课堂放电像银角大王 网友:别拦我我要去上物理课2023-10-13 13:45:05近日,四川成都,四川师范大学,一名物理老师在课堂上亲自演示特斯拉线圈放电。老师身穿防护装备,好似西游记里银角大王。整个实验过程充满
大学物理老师课堂放电像银角大王 网友:别拦我我要去上物理课2023-10-13 13:45:05近日,四川成都,四川师范大学,一名物理老师在课堂上亲自演示特斯拉线圈放电。老师身穿防护装备,好似西游记里银角大王。整个实验过程充满


















